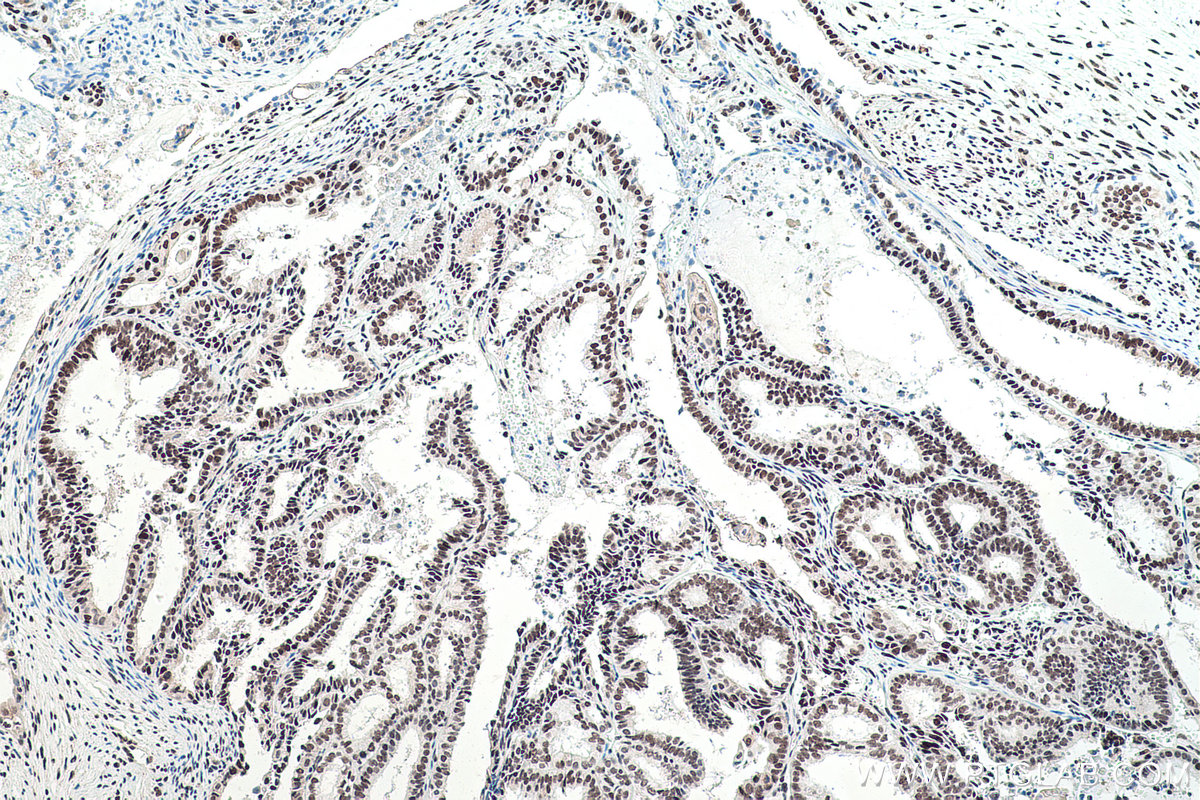

IHCeasy® FUS/TLS Ready-To-Use IHC Kit
FUS/TLS Ready-to-use reagent kit for IHC.
Cat no : KHC0057
Synonyms
75 kDa DNA pairing protein, FUS, FUS1, FUS-CHOP, hnRNP P2, Oncogene FUS, Oncogene TLS, POMp75, RNA binding protein FUS, TLS, TLS/CHOP
Validation Data Gallery
Product Information
KHC0057 is a ready-to-use IHC kit for staining of FUS. The kit provides all reagents, from antigen retrieval to cover slip mounting, that require little to no diluting or handling prior to use. Simply apply the reagents to your sample slide according to the protocol and you're steps away from obtaining high-quality IHC data.
| Product name | IHCeasy FUS/TLS Ready-To-Use IHC Kit |
| Sample type | FFPE tissue |
| Assay type | Immunohistochemistry |
| Primary antibody type | Rabbit Polyclonal |
| Secondary antibody type | Polymer-HRP-Goat anti-Rabbit |
| Reactivity | Human, Mouse, Rat |
Kit components
| Component | Size | Concentration |
|---|---|---|
| Antigen Retrieval Buffer | 100 mL | 50× |
| Washing Buffer | 100 mL ×2 | 20× |
| Blocking Buffer | 5 mL | RTU |
| Primary Antibody | 5 mL | RTU |
| Secondary Antibody | 5 mL | RTU |
| Chromogen Component A | 0.2 mL | RTU |
| Chromogen Component B | 4 mL | RTU |
| Signal Enhancer | 5 mL | RTU |
| Counter Staining Reagent | 5 mL | RTU |
| Mounting Media | 5 mL | RTU |
| Datasheet | 1 Copy | |
| Manual | 1 Copy |
Background Information
FUS (also named TLS and POMp75) belongs to the RRM TET family. FUS may play a role in the maintenance of genomic integrity; it binds both single-stranded and double-stranded DNA and promotes ATP-independent annealing of complementary single-stranded DNAs and D-loop formation in superhelical double-stranded DNA. FUS is also an RNA-binding protein, and its links to neurodegenerative disease proffer the intriguing possibility that altered RNA metabolism or RNA processing may underlie or contribute to neuron degeneration. It has been reported that FUS is present in 5% of the pathalogical aggregations (inclusions) seen in familial amyotrophic sclerosis (fALS). FUS-positive inclusions were also reported in cases of sporadic ALS (sALS). More recently, wild-type FUS has also been implicated in the pathological development of frototemporal lobar dementia (FTLD) with ubiquitin-positive inclusions (FTLD-U), further linking FUS to the pathogenesis of neurogenerative diseases. There is some debate as to whether FUS colocalizes with TDP-43 in TDP-43-positive cases of ALS and whether TDP-43 and FUS cause neurodegenerative disease independently or contributively of one another.
Properties
| Storage Instructions | All the reagents are stored at 2-8°C. The kit is stable for 6 months from the date of receipt. |
| Synonyms | 75 kDa DNA pairing protein, FUS, FUS1, FUS-CHOP, hnRNP P2, Oncogene FUS, Oncogene TLS, POMp75, RNA binding protein FUS, TLS, TLS/CHOP |
Publications
| Application | Title |
|---|---|
Cell Death Dis Specific intracellular retention of circSKA3 promotes colorectal cancer metastasis by attenuating ubiquitination and degradation of SLUG |